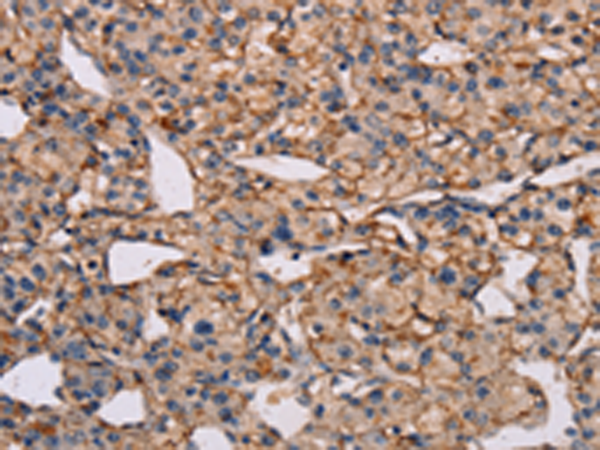

-
分类: 科研抗体货号: P11848别名: CRL4; EVI27; IL17BR; IL17RH1应用: WB,IHC反应种属: Human
-
分类: 科研抗体货号: P11846别名: IL27; IL-27; IL-17D应用: WB,IHC反应种属: Human
-
分类: 科研抗体货号: P11864别名: MUM1; LSIRF; NF-EM5应用: WB反应种属: Human, Mouse
-
分类: 科研抗体货号: P11844别名:应用: IHC反应种属: Human
-
分类: 科研抗体货号: P11882别名: KIF4; KIF4G1应用: IHC反应种属: Human, Mouse
-
分类: 科研抗体货号: P11863别名: FABPI; I-FABP应用: WB,IHC反应种属: Human, Mouse, Rat
-
分类: 科研抗体货号: P11875别名: KT3.2; TASK3; K2p9.1; TASK-3应用: WB,IHC反应种属: Human
-
分类: 科研抗体货号: P11881别名: KID; OBP; KNSL4; OBP-1; OBP-2; SEMDJL2; A-328A3.2应用: WB,IHC反应种属: Human
-
分类: 科研抗体货号: P11862别名: FABPL; L-FABP应用: WB反应种属: Human, Mouse, Rat
-
分类: 科研抗体货号: P11874别名: KV6.3; KV6.4应用: WB,IHC反应种属: Human, Mouse

鄂公网安备42018502007531号
鄂公网安备42018502007531号

